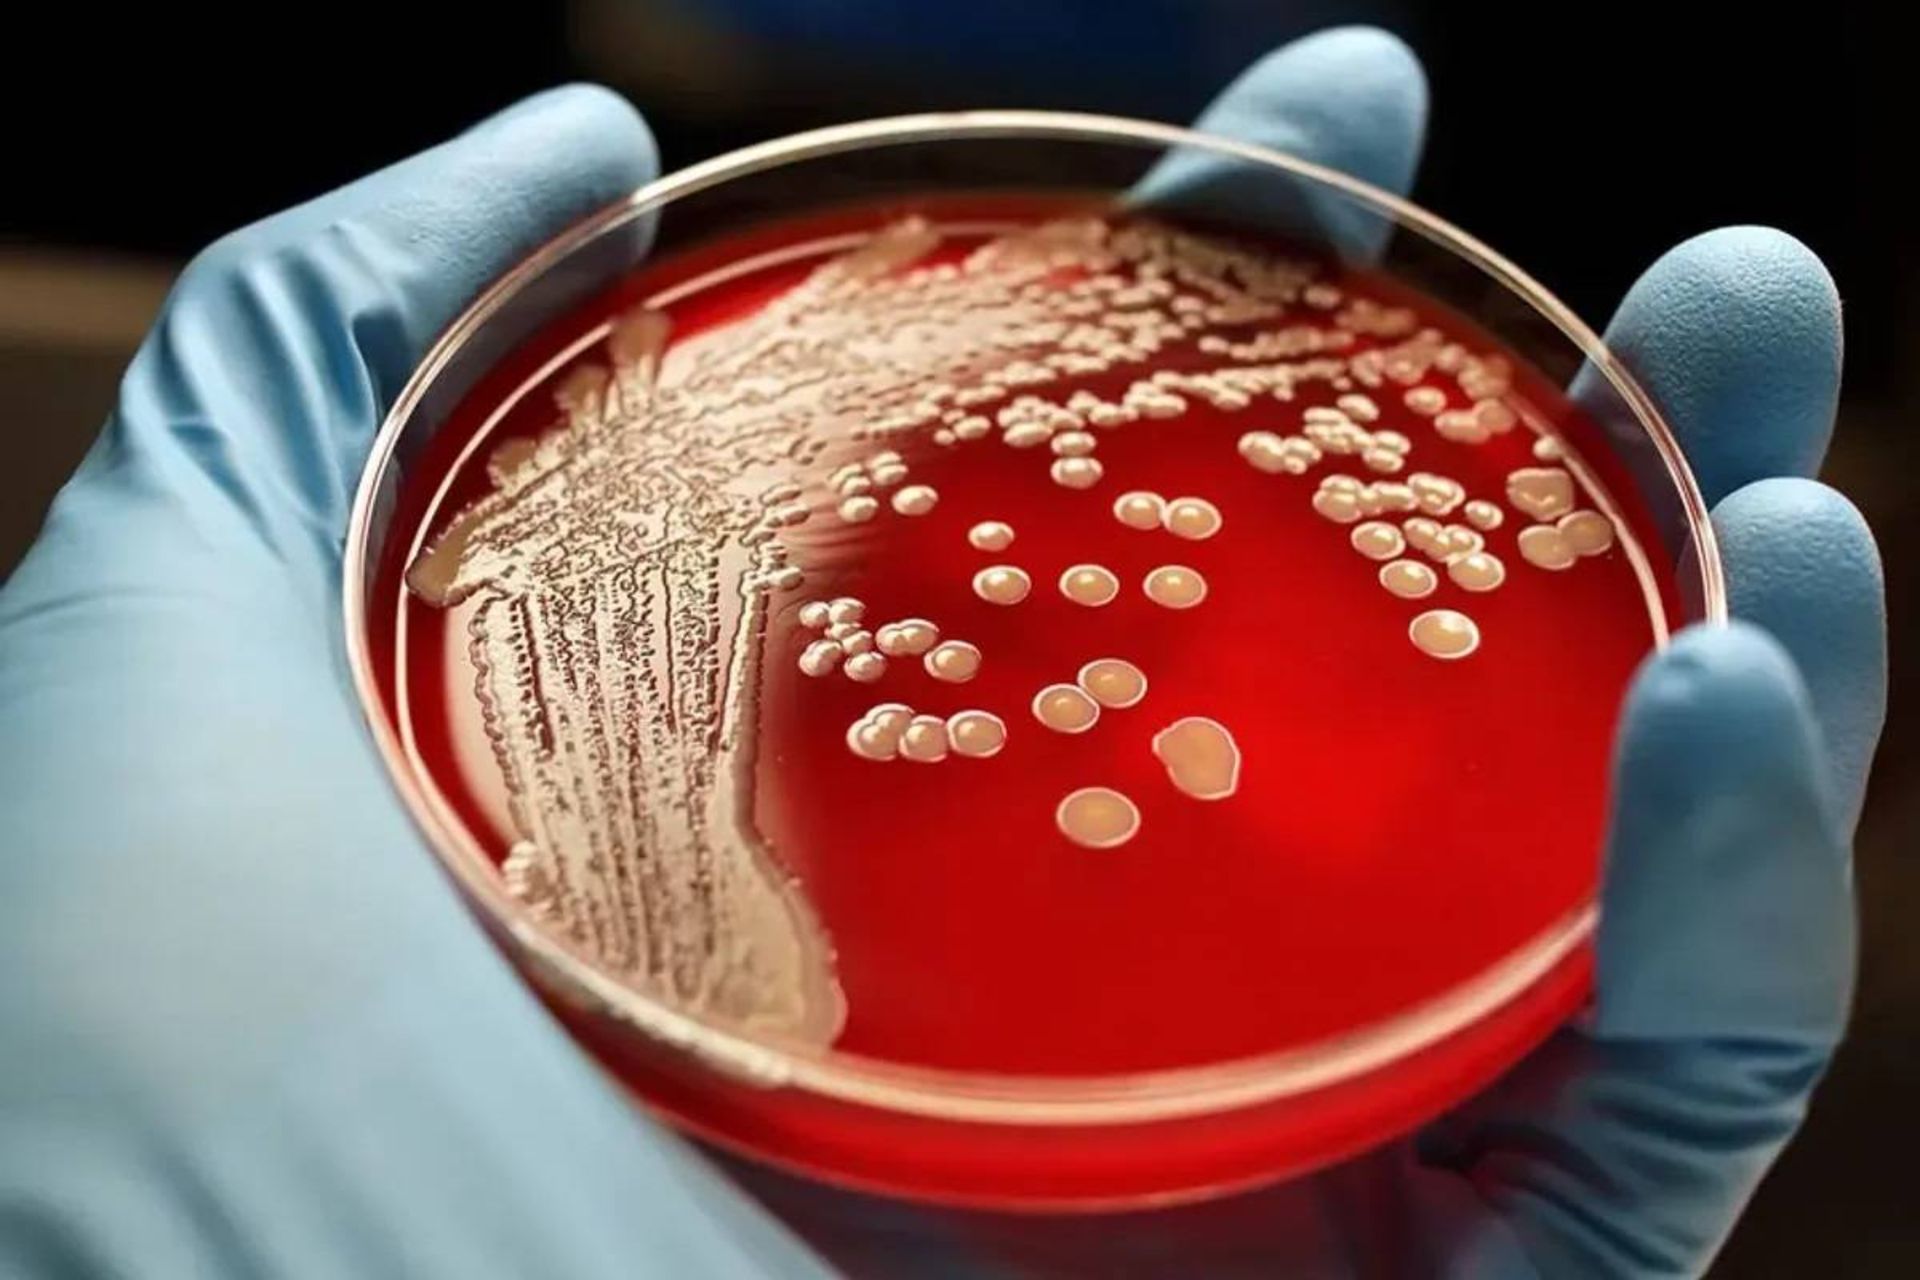
کشت باکتری

باکتریها چگونه میتوانند در برابر داروهایی که هنوز ساخته نشدهاند، مقاوم شوند؟
آیا باکتریها بهطور تصادفی جهش پیدا میکنند یا جهشهای آنها هدفمند است؟ پژوهشگران بیش از یک قرن درمورد این موضوع سردرگم بودهاند.
در سال ۱۹۴۳ سالوادور لوریا میکروبشناس و ماکس دلبروک، فیزیکدانی که به زیستشناسی روی آورد، آزمایشی را ابداع کردند تا استدلال کنند که باکتریها بدون هدف جهش پیدا میکنند. دانشمندان دیگر با استفاده از آزمایش آنها نشان دادند که باکتریها میتوانند دربرابر آنتیبیوتیکهایی که قبلا با آنها مواجه نشدهاند، مقاومت کسب کنند.
آزمایش لوریا-دلبروک تاثیر قابلتوجهی بر علم داشت. یافتهها به لوریا و دلبروک کمک کرد تا در سال ۱۹۶۹ جایزه نوبل فیزیولوژی یا پزشکی را از آن خود کنند. دههها بعد، این آزمایش همچنان آموزههای مهمی ارائه و نشان میدهد باکتریها میتوانند دربرابر آنتیبیوتیکهایی که هنوز ساخته نشدهاند، مقاومت کسب کنند.
ماشین پوکر و لحظه کشف
لوله آزمایش حاوی باکتریهایی را تصور کنید که در سوپی از مواد مغذی زندگی میکنند. سوپ به دلیل غلظت بالای باکتریهای درون آن کدر است. افزودن ویروسی به لوله آزمایش که باکتریها را آلوده میکند و فاژ نامیده میشود، بیشتر باکتریها را میکشد و سوپ را شفاف میکند. هرچند، اگر لوله آزمایش در شرایط مناسب برای رشد باکتریها نگه داشته شود، دوباره با گذشت زمان سوپ کدر میشود. این امر نشان میدهد باکتریها دربرابر فاژها مقاومت کسب کردهاند و میتوانند تکثیر شوند. فاژها چه نقشی در این تغییر داشتند؟
در گذشته، برخی از دانشمندان فکر میکردند فاژها موجب میشوند باکتریها در راستای بقا جهش پیدا کنند. دیگران پیشنهاد میکردند باکتریها بهطور منظم جهش پیدا میکنند و ایجاد گونههای مقاوم دربرابر فاژ شانسی است. لوریا و دلبروک ماهها برای حل این معما با هم همکاری کردند، اما هیچیک از آزمایشهای آنها موفق نبود.
در شب ۱۶ ژانویه سال ۱۹۴۳، لوریا هنگام تماشای همکارش که با دستگاه پوکر بازی میکرد، راهحلی برای کشف این معما پیدا کرد. او صبح روز بعد به آزمایشگاهش رفت.
آزمایش لوریا شامل چند لوله و پتری دیش بود. هر لوله حاوی مواد مغذی بود که به تکثیر باکتری ایکولای کمک میکرد، درحالیکه هر پتری دیش حاوی مواد پوشیدهشده با فاژ بود. چند باکتری در هر لوله قرار داده و فرصتی برای تولید گونهی مقاوم دربرابر فاژ به آنها داده شد. آنها میتوانستند در غیاب فاژ در لولهها یا در حضور فاژها در پتری دیش جهش پیدا کنند.

روز بعد، لوریا باکتریهای درون هر لوله را به ظرف پر از فاژ منتقل و روز آینده تعداد کلنیهای باکتریایی مقاوم در هر ظرف را شمارش کرد. اگر باکتریها طی تعامل با فاژها، در برابر آنها مقاومت کسب میکردند، نباید هیچیک از باکتریهای درون لولهها دارای جهش میبودند. از سوی دیگر، وقتی باکتریها به ظرف حاوی فاژ منتقل میشوند، باید تعداد کمی از آنها (مثلا یک از ۱۰ میلیون باکتری) گونههای مقاوم تولید کنند. هر گونهی مقاوم دربرابر فاژ باید به شکل یک کلنی رشد کند، اما سایر باکتریها باید براثر عفونت از بین بروند.
اگر باکتریها مستقل از تعامل با فاژها، مقاومت به دست آورند، برخی از باکتریهای درون لولهها دارای جهش خواهند بود. علت آن است که هر بار که باکتری درون لوله تقسیم میشود، احتمال کمی وجود دارد که گونهی مقاومی تولید کند. اگر نسل آغازینِ باکتری، اولین نسلی باشد که جهش پیدا میکند، حداقل نیمی از باکتریها در نسلهای بعدی مقاوم خواهند بود. اگر باکتری نسل دوم، اولین باکتری باشد که جهش پیدا میکند، حداقل یکهشتم از باکتریها در نسلهای بعدی مقاوم خواهند بود.
مانند جایزههای کوچک درون ماشین پوکر، جهشهای نسل آخر بیشتر اتفاق میافتد، اما تعداد کمتری گونهی مقاوم حاصل میکند و مانند جایزههای بزرگ، جهشهای نسل اولیه بهندرت اتفاق میافتند، اما گونههای زیادی را حاصل میکنند. جهشهای نسل اولیه نادر هستند، زیرا در آن اوایل تعداد کمی باکتری برای جهش پیدا کردن وجود دارد. برای مثال، در آزمایش نسل بیستم، جهشی که در نسل دهم باکتری رخ میدهد، ۱۰۲۴ گونهی مقاوم به فاژ ایجاد میکند و جهشی که در نسل هفدهم رخ میدهد، تنها چهار گونه مقاوم به فاژ حاصل میکند.
تعداد کلنیهای مقاوم در آزمایشهای لوریا، الگوی مشابه الگوی پول نقد ماشینهای پوکر را نشان میداد. بیشتر ظرفها حاوی کلنیهای جهشیافته نبودند یا حاوی تعداد کمی کلنی جهشیافته بودند، اما چندین مورد، تعداد زیادی کلنی جهشیافته داشتند که لوریا آنها را جایزه بزرگ درنظر گرفت. این بدان معنا بود که باکتریها قبل از اینکه درون ظرفها با فاژها تعامل داشته باشند، گونههای مقاوم را تولید کرده بودند.
میراث آزمایش لوریا
لوریا پس از تکمیل آزمایش، یادداشتی برای دلبروک نوشت و از او خواست آزمایشهای او را بررسی کند. سپس دو دانشمند با همکاری هم مقالهی کلاسیکی را نوشتند که پروتکل آزمایشی و چارچوب نظری را برای اندازهگیری نرخ جهش باکتریها توصیف میکرد.

دانشمندان دیگر آزمایشهای مشابهی با جایگزینی فاژها با پنیسیلین و داروهای سل انجام دادند. آنها نیز دریافتند که باکتریها برای دستیابی به مقاومت، نیازی به مواجهه با آنتیبیوتیک ندارند.
میلیونها سال است باکتریها برای مقابله با شرایط محیطی نامساعد و درحال تغییر به جهشهای تصادفی متکی بودهاند. جهشهای بیوقفه و تصادفی آنها موجب میشود گونههایی را ایجاد کنند که به ناگزیر درمقابل آنتیبیوتیکهای آینده مقاوم هستند. مقاومت نسبت به داروها یکی از واقعیتهای زندگی است که باید آن را بپذیریم و به مبارزه با آن ادامه دهیم.

